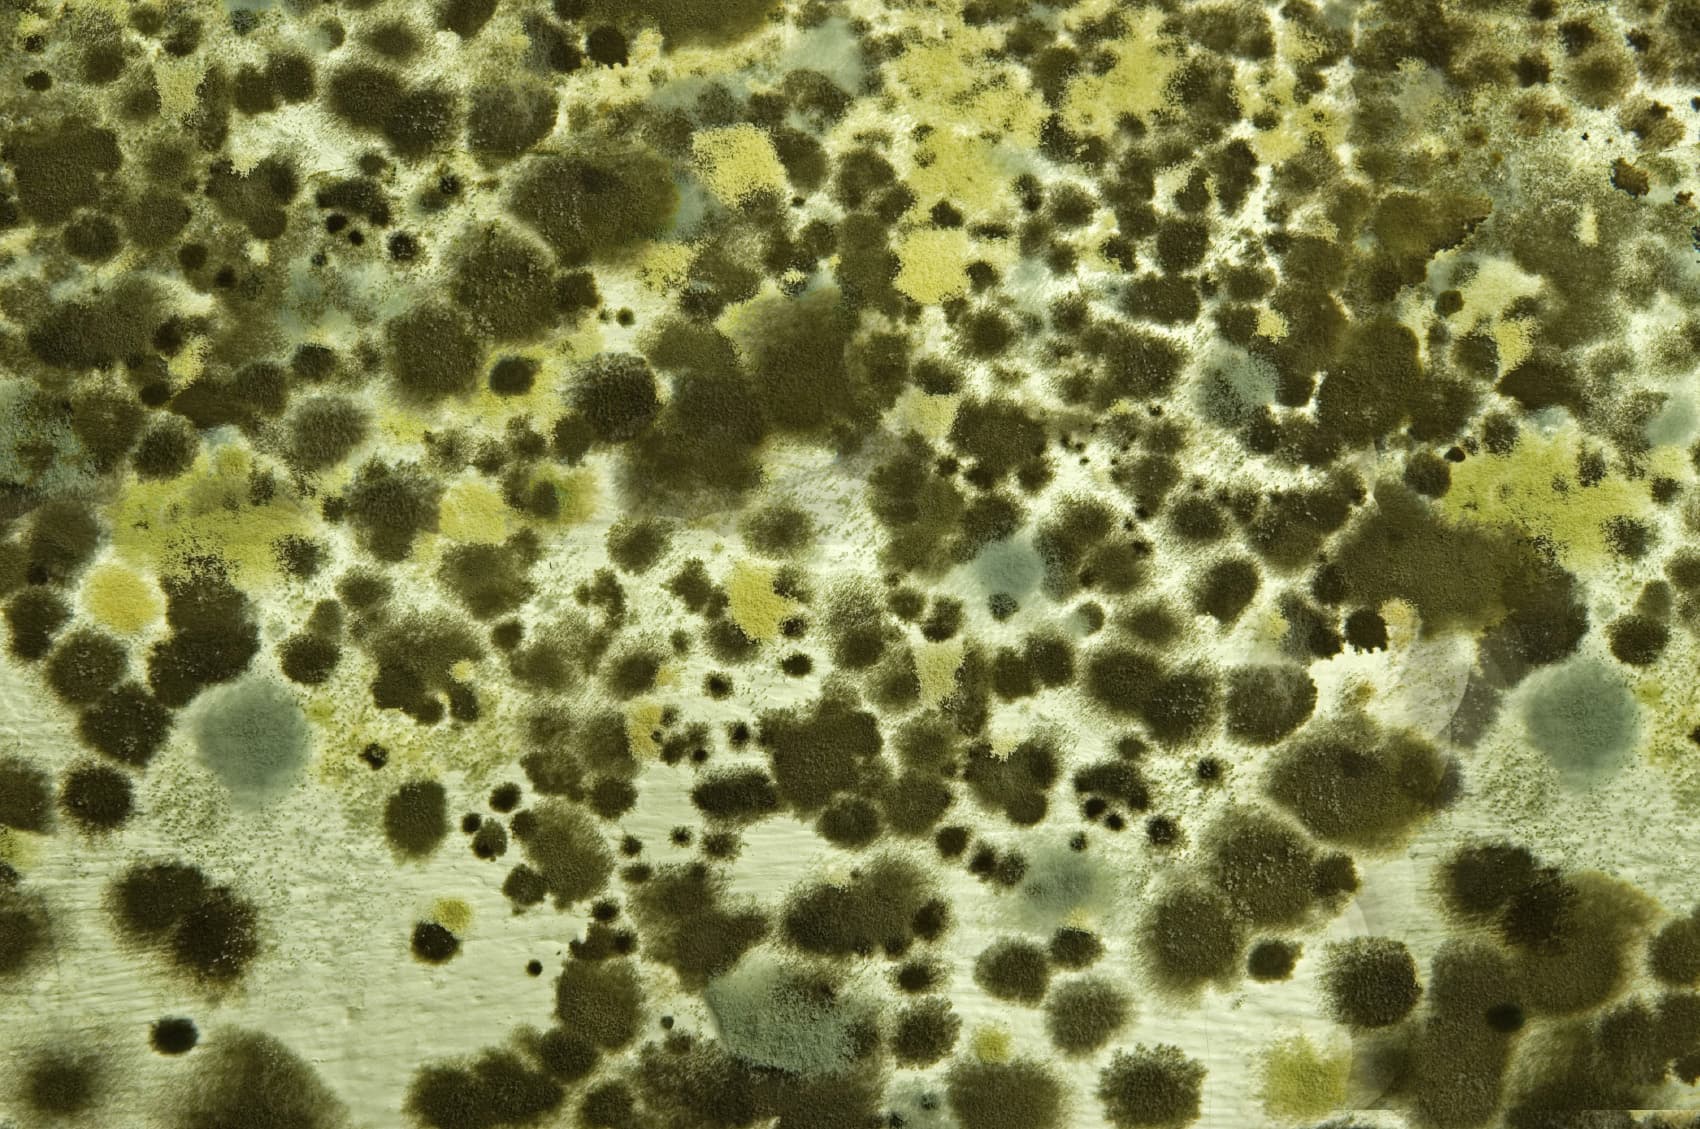
Mould growth on a surface

Chemical testing for the air you breathe, the spaces you build, and the materials you make.
CASSEN Testing Laboratories is a Toronto-based AIHA-LAP (ISO 17025) accredited chemical testing laboratory. Since 2000 we've delivered analytical services in environmental health, occupational health, forensic investigation, LEED / green-building certification, and specialized studies for clients across Canada and internationally.
- Established
- 2000
- VOCs resolved
- ~300
- Standard TAT
- 5 days
- CompoundBenzene
- Conc.3.2 µg/m³
- MethodTO-17
- StatusPASS
Illustrative chromatogram. We resolve up to ~300 compounds in a single indoor air sample using thermal-desorption GC-MS.
Find your path
Trusted analytical partner for
- Health Canada
- •
- Statistics Canada
- •
- Environment & Climate Change Canada
- •
- Ontario Ministry of Labour
- •
- DRDC
- •
- Cancer Care Ontario
- •
- University of Ottawa
See Publications & Research for selected studies.
Why CASSEN
Chemical testing built for complex real-world samples.
ISO 17025 accredited
AIHA-LAP (ISO/IEC 17025) with one of the largest scopes of accredited parameters of any laboratory internationally.
Unknown-compound expertise
Thermal-desorption GC-MS can detect up to ~300 compounds in a single indoor air sample — ideal for odour and vapour-intrusion investigations.
LEED-ready since 2010
IEQ testing for LEED, WELL, and Green Globes — delivered on construction schedules with calibrated supplies you can rent.
Rush turnaround available
From 5-business-day standard down to same-day analysis when you need it. Transparent surcharge schedule published in advance.
What we test
Five core service areas cover the bulk of our work. Specialized analytical packages cover the rest — from mould MVOCs to arson accelerants to plastic emission characterization.

Environmental Health
Indoor and ambient air quality, workplace investigations, odour and industrial process emissions, landfill emission characterization, and biological monitoring.
See parameters
Occupational Health
Industrial hygiene and occupational exposure evaluations to protect workers and meet regulatory requirements.
See parameters
Forensic Investigation
Analytical support for arson, controlled-substance, and litigation matters with data interpretation backed by expert testimony.
See parameters
Green Building & LEED
IEQ testing for LEED, WELL, and Green Globes projects. CASSEN has delivered LEED air-quality testing since 2010 with turnaround times that fit construction schedules.
See parameters
Plastic Emissions
Analysis of plastic precursors, additives, and decomposition by-products using GC/MS headspace and targeted methods.
See parametersSpecialized services
The long tail of analytical packages.
Beyond the core service areas, we run targeted packages for mould indicators, renovation off-gassing, illicit drugs, smoke characterization, landfill emissions, and more.
Selected case studies
Programs that show what the lab is capable of.
Four representative engagements — national-scale biomonitoring, a headline class action, a constrained-environment defence project, and an active longitudinal study. See Publications for the full list.
- Statistics Canada · Health Canada2009 – 2014Nationalbiomonitoring programme
Canadian Health Measures Survey (CHMS)
Multi-year analytical service for the national CHMS, characterizing exposure to organic compounds across a representative Canadian cohort.
Read more - Health Canada20081,200 homesinvestigated
Retrofoam Formaldehyde Class Action
Indoor-air formaldehyde analysis across 1,200 residential properties to support the national Retrofoam insulation class-action investigation.
Read more - Defence R&D Canada2005Under pressureVictoria-class submarine
Submarine Air-Quality Characterization
Analytical workup of cabin atmosphere aboard a Victoria-class submarine — one of the most constrained environments in which VOC monitoring has been performed.
Read more - Health Canada · U Ottawa2020 – 203094 compoundsper dwelling
First Nation Indoor-Air Study
Longitudinal indoor-air exposure assessment in First Nation communities — targeted panel of 94 organic compounds, ongoing.
Read more
How it works
From quote to report in four steps.
- 01
Request a quote
Tell us the analytes, matrix, and target date. We respond within one business day.
- 02
Receive sampling kit
Pre-calibrated SKC / Gillian pumps, sorbent media, BIOS calibrators — shipped to you.
- 03
Collect & ship samples
Use the chain-of-custody form, ship to 51 International Blvd. Day 0 starts on receipt.
- 04
Get your report
Standard 5 business days; rush options down to same-day. PDF + structured data on request.
Turnaround
5 days standard. Same-day available.
Rush surcharges from +25% (96-hour) to +200% (same day). Surcharge schedule is published — no surprises on the invoice.
Credentials & standards
Methods accredited under ISO/IEC 17025 and externally verified through continuous proficiency testing.

- AIHA-LAP LLCISO/IEC 17025 accreditation
- IHPATIndustrial Hygiene PAT
- LGC Standards PTUK proficiency testing
- Phenova PTInter-laboratory comparison
Ready to submit samples?
Open a portal account to submit samples online, download chain-of-custody forms, request calibrated pumps and media, and track report status in real time.